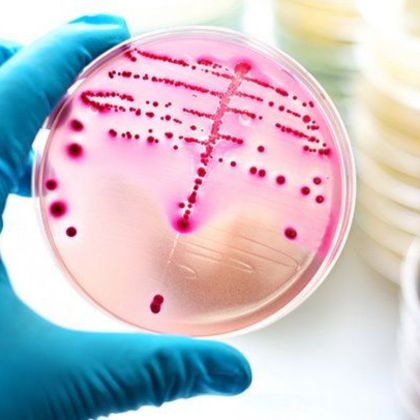
Bakterie z rodzaju Streptococcus

I. Wprowadzenie
A. Czym jest różyca?
Różyca, zwana również różanką, jest ostrym, zakaźnym schorzeniem skóry, charakteryzującym się czerwoną, opuchniętą i bolesną zmianą skórną, zazwyczaj na twarzy. Choroba ta jest wywołana przez bakterie z rodzaju Streptococcus.
B. Dlaczego warto poznać tę chorobę?
Poznanie różyca jest istotne ze względu na jej natychmiastowe leczenie, aby uniknąć powikłań oraz rozprzestrzenienia się infekcji.
C. Krótkie dane statystyczne i występowanie
Różyca występuje na całym świecie, jednak najczęściej diagnozuje się ją u osób starszych. Zarażenie różyca występuje przeważnie u osób z osłabionym układem odpornościowym, co może prowadzić do poważnych konsekwencji, jeśli nie zostanie szybko zdiagnozowane i leczone.
II. Podstawy medyczne
A. Definicja i klasyfikacja różycy
Różyca, jako ostre zakażenie skóry, jest klasyfikowana jako zakażenie bakteryjne. Może występować w różnych postaciach, w tym typowej różyczce twarzy, różyce rąk i nóg oraz uogólnionej różyczce, która dotyka całego ciała.
B. Różnica między różycą a innymi infekcjami skóry (np. cellulitis, liszajec)
Różnica między różycą a innymi infekcjami skóry, takimi jak cellulitis czy liszajec, polega na różnych patogenezach oraz wywołujących je patogenach.
- Cellulitis to zapalenie tkanki podskórnej, często wywołane przez bakterie, takie jak Streptococcus pyogenes lub Staphylococcus aureus.
- Natomiast liszajec to zakaźne zapalenie skóry spowodowane przez wirusa, które objawia się jako wysypka.
- Różyca ma charakterystyczne cechy, takie jak ostre początki, opuchlizna, zaczerwienienie i ból, które odróżniają ją od innych infekcji skórnych.
III. Przyczyny i czynniki ryzyka
A. Bakteria wywołująca różycę: Streptococcus pyogenes
Różyca jest spowodowana zakażeniem bakterią Streptococcus pyogenes, również znana jako paciorkowiec ropotwórczy Grupy A. Ta bakteria jest głównym czynnikiem etiologicznym tego schorzenia i może łatwo przenosić się poprzez kontakt z zakażonymi osobami lub przedmiotami.
B. Czynniki sprzyjające zakażeniu
Najczęstszymi czynnikami sprzyjającymi zakażeniu różycą są:
- rany skóry,
- zranienia,
- zaburzenia odporności
- oraz choroby przewlekłe, takie jak cukrzyca czy niewydolność serca.
Osoby z uszkodzoną barierą skórną (np. poprzez otarcia, ranki czy owrzodzenia) są bardziej narażone na zakażenie.
C. Grupy podwyższonego ryzyka
Poszczególne grupy ludności, takie jak osoby starsze, osoby z cukrzycą, pacjenci z obniżoną odpornością lub osoby mieszkające w warunkach zbiorowych, są podwyższonym ryzykiem zachorowania na różycę. Osoby starsze i te z chorobami przewlekłymi mogą mieć osłabiony system odpornościowy, co czyni je bardziej podatnymi na infekcje bakteryjne, takie jak różycą.
IV. Drogi zakażenia
A. Jak dochodzi do infekcji?
Infekcja różycą rozpoczyna się poprzez kontakt z zakażonymi osobami lub przedmiotami przenoszącymi bakterię Streptococcus pyogenes. Najczęstsze drogi zakażenia obejmują bezpośredni kontakt skóry do skóry, jak również kontakt z zakażonymi wydzielinami, takimi jak ślina, katar lub ropne wydzieliny.
B. Czy różyca jest zaraźliwa?
Tak, różycą jest chorobą zakaźną. Bakteria Streptococcus pyogenes, która jest jej przyczyną, może łatwo przenosić się z osoby na osobę poprzez bliski kontakt. Dlatego też istnieje ryzyko zarażenia się różycą od chorych osób, zwłaszcza jeśli mają one otwarte rany lub owrzodzenia skóry.
C. Możliwości przenoszenia choroby
Różycę można przenosić poprzez różne sposoby, takie jak:
- Bezpośredni kontakt skóry do skóry
- Kontakt z zakażonymi wydzielinami, jak ślina czy wydzieliny z nosa
- Dotykanie skażonych przedmiotów, na przykład ręczników, ubrań czy przyborów toaletowych zakażonych osób
Ważne jest zachowanie higieny, unikanie kontaktu z zakażonymi osobami oraz dbanie o rany i uszkodzenia skóry, aby zmniejszyć ryzyko zakażenia różycą.
V. Objawy kliniczne, diagnostyka i leczenie
A. Objawy kliniczne

- Wczesne objawy różycy: W początkowej fazie różycy mogą wystąpić objawy takie jak rumień, obrzęk, ból, ciepłota i pulsacja w miejscu infekcji.
- Charakterystyczne zmiany skórne: Charakterystyczne zmiany skórne to obrzęk, zaczerwienienie, ciepłota i bolesność na obszarze dotkniętym infekcją. Mogą występować także pęcherze i pęcherzyki.
- Objawy ogólnoustrojowe: Oprócz objawów skórnych, pacjenci z różycą mogą odczuwać gorączkę, dreszcze oraz ogólne osłabienie organizmu.
- Odmiany kliniczne różycy: Istnieją różne odmiany kliniczne różycy, takie jak różyca twarzy czy różyca kończyn. Objawy mogą być różne w zależności od miejsca infekcji.
B. Diagnostyka
- Wywiad lekarski i badanie fizykalne: Lekarz przeprowadza wywiad oraz badanie fizykalne, aby ocenić objawy i zmiany skórne pacjenta.
- Diagnostyka różnicowa: Konieczne jest wykluczenie innych chorób przypominających objawami różycę, takich jak zapalenie skóry czy inne infekcje bakteryjne.
- Badania laboratoryjne i obrazowe: Czasami mogą być zlecone badania krwi, aby potwierdzić obecność infekcji bakteryjnej. Obrazy diagnostyczne, jak np. zdjęcia rentgenowskie, mogą być pomocne przy diagnozie.
- Znaczenie szybkiej diagnozy: Szybka diagnoza i rozpoczęcie leczenia są kluczowe dla skutecznego zwalczania różycy i zapobiegania powikłaniom.
C. Leczenie
- Farmakoterapia: Leczenie różycy obejmuje zazwyczaj antybiotyki, szczególnie penicylinę. Ważne jest skończenie całego przebiegu antybiotykoterapii, nawet jeśli objawy już ustąpiły.
- Leczenie wspomagające: Oprócz antybiotyków, pacjent może potrzebować odpoczynku, nawodnienia oraz łagodzenia objawów, takich jak ból i gorączka.
- Leczenie szpitalne vs. ambulatoryjne: W cięższych przypadkach lub gdy występują powikłania, konieczne może być leczenie szpitalne. W przypadku łagodniejszych objawów, pacjent może być leczony ambulatoryjnie.
- Jak długo trwa leczenie?: Czas trwania leczenia różycy zależy od nasilenia infekcji i odpowiedzi pacjenta na terapię. Zazwyczaj leczenie trwa od kilku dni do kilku tygodni.
Pamiętaj, że leczenie różycy powinno być zawsze prowadzone pod nadzorem lekarza, a wszelkie wątpliwości dotyczące objawów czy terapii należy omówić z profesjonalistą medycznym.
VI. Powikłania i zapobieganie
A. Powikłania
- Najczęstsze powikłania: Różyca może prowadzić do wystąpienia ropowicy, czyli miejscowego ropienia skóry, który może być bolesny i wymagać antybiotykoterapii. Ponadto, zakażenie może też być powodem rozwoju zakrzepicy żylnej, która polega na tworzeniu się skrzepu w żyłach, co może prowadzić do poważnych problemów zdrowotnych.
- Różyca nawracająca – przyczyny i zapobieganie: Różyca nawracająca może być wynikiem nieprawidłowego leczenia lub braku należytej opieki nad skórą. Zapobieganie nawrotom różyca może wymagać długoterminowego leczenia antybiotykami, dbałości o higienę skóry oraz wdrożenia specjalnych środków profilaktycznych.
- Kiedy różyca może zagrażać życiu? Choć zazwyczaj różyca jest chorobą łagodną, w niektórych przypadkach może zagrażać życiu, zwłaszcza gdy dochodzi do rozwoju powikłań takich jak sepsa czy toksyczny zespół wstrząsu określany mianem zespołu poprzeszczepowego.

B. Zapobieganie
- Higiena skóry i unikanie urazów: Zapobieganie różycy obejmuje zachowanie wysokiej higieny skóry poprzez regularne mycie i pielęgnację oraz unikanie wszelkich urazów, które mogłyby prowadzić do powstania otwartych ran na skórze, przez które zarazki mogłyby się przedostać.
- Znaczenie leczenia chorób współistniejących: Ważne jest leczenie chorób współistniejących, które mogą osłabiać naturalną odporność organizmu, co zwiększa ryzyko wystąpienia różyca.
- Edukacja pacjentów i profilaktyka nawrotów: Edukacja pacjentów na temat późnych objawów różyca oraz prowadzenie odpowiedniej profilaktyki, a także kontrola stanu zdrowia po zakończeniu kuracji antybiotykowej, są kluczowe dla zapobiegania nawrotom choroby.
VII. Różyca a choroby współistniejące
A. Cukrzyca i różyca
Cukrzyca może zwiększać ryzyko wystąpienia różycy ze względu na obniżoną odporność i zaburzenia krążenia, co może predysponować do powstania zakażeń skórnych. Ponadto, zakażenia u osób z cukrzycą mogą być trudniejsze do wyleczenia, co może prowadzić do powikłań i nawrotów różycy. Dlatego osoby z cukrzycą powinny szczególnie dbać o higienę skóry, unikać urazów oraz monitorować uważnie stan swojej skóry.
B. Choroby układu limfatycznego
Choroby układu limfatycznego, takie jak np. przewlekła niewydolność limfatyczna czy obrzęk limfatyczny, mogą zwiększać ryzyko wystąpienia różycy poprzez zaburzenie drenażu limfy i osłabienie obrony organizmu przed infekcjami. Osoby cierpiące na te schorzenia powinny być szczególnie ostrożne i skonsultować się z lekarzem w przypadku jakichkolwiek objawów skórnych.
C. Problemy immunologiczne
Osoby z zaburzeniami immunologicznymi, takimi jak HIV/AIDS, autoimmunologiczne choroby skóry czy stosowanie leków immunosupresyjnych, mogą być bardziej podatne na zakażenia różycą ze względu na obniżoną odporność organizmu. W takich przypadkach, profilaktyka różycy oraz monitorowanie stanu skóry są kluczowe dla zapobiegania powikłaniom.
VIII. Różyca u szczególnych grup
A. Dzieci i niemowlęta
U dzieci i niemowląt różycę często można zauważyć jako rumień lub wysypkę na skórze. Obserwowanie stanu skóry oraz szybkie zwracanie uwagi na jakiekolwiek zmiany pozwala na szybkie zdiagnozowanie choroby i podjęcie odpowiedniego leczenia.
Ponadto, dzieci i niemowlęta mają delikatną skórę, przez co są bardziej podatne na podrażnienia, które mogą prowadzić do rozwoju różycy.
B. Osoby starsze
U osób starszych różycę często można spotkać w okolicach fałdów skórnych, takich jak pachwiny, pachy czy pod piersiami. Ze względu na zmniejszoną elastyczność skóry u osób starszych, łatwiej mogą się tam pojawiać zakażenia grzybicze, które mogą prowadzić do różycy. Stała obserwacja stanu skóry oraz odpowiednia higiena są kluczowe w prewencji i leczeniu różycy u tej grupy wiekowej.
C. Kobiety w ciąży

Kobiety w ciąży mogą być bardziej podatne na różycę ze względu na zmiany hormonalne, które mogą wpływać na kondycję skóry. Ponadto, ze względu na wzrost wilgotności w okolicach fałdów skórnych podczas ciąży, może to sprzyjać rozwojowi zakażeń skórnych, w tym różycy.
Dlatego ważne jest, aby kobiety w ciąży dbały o higienę skóry, unikały nadmiernego pocenia się oraz regularnie sprawdzały stan swojej skóry pod kątem wystąpienia objawów różycy. Dodatkowo, w przypadku jakichkolwiek podejrzeń, należy skonsultować się z lekarzem w celu właściwej diagnozy i leczenia.
IX. Aspekty społeczne i psychologiczne
A. Wpływ choroby na jakość życia
Różyca, będąc chorobą skórną, może wpłynąć negatywnie na jakość życia pacjentów. Objawy choroby, takie jak swędzenie, pieczenie czy ból skóry, mogą powodować dyskomfort i utrudniać codzienne funkcjonowanie. Może to prowadzić do zmniejszenia komfortu życia oraz wpływać na samopoczucie i emocje pacjenta.
B. Stygmatyzacja związana ze zmianami skórnymi
- Zmiany skórne występujące w przebiegu różycy mogą być źródłem stygmatyzacji społecznej.
- Pacjenci mogą doświadczać dyskryminacji lub niestosownych komentarzy ze strony innych osób ze względu na widoczne objawy choroby.
- To może prowadzić do obniżenia poczucia własnej wartości, izolacji społecznej oraz problemów emocjonalnych.
C. Potrzeba wsparcia psychicznego
Pacjenci z różycą często potrzebują wsparcia psychicznego, aby poradzić sobie z wyzwaniami, jakie niesie choroba. Może to obejmować zarówno wsparcie emocjonalne od bliskich, jak i profesjonalne wsparcie psychologiczne.
Terapia psychologiczna może pomóc pacjentom radzić sobie ze stresem związanym z chorobą, zwiększyć poczucie własnej wartości oraz nauczyć skutecznych strategii radzenia sobie z negatywnymi emocjami związanymi z doświadczeniem różycy. Wsparcie w sferze psychologicznej jest istotnym aspektem leczenia i powrotu do pełni zdrowia.
X. Różyca w weterynarii i zoonozy
A. Różyca u zwierząt – czy to ta sama choroba?
Różyca występująca u ludzi i zwierząt to dwie różne choroby. Różyca u ludzi jest wywołana przez bakterię Streptococcus pyogenes, podczas gdy różyca u zwierząt jest spowodowana innymi szczepami bakterii z rodzaju Streptococcus. Chociaż objawy mogą wydawać się podobne, to są to jednak odrębne choroby z różnymi przyczynami i drogami zakażenia.
B. Możliwość przeniesienia ze zwierząt na ludzi
Różyca u zwierząt może stanowić zagrożenie zoonotyczne, czyli istnieje potencjalna możliwość przeniesienia zakażenia z zwierząt na ludzi. Chociaż zoonozy związane z różycą są rzadkie, to warto zachować ostrożność w kontakcie ze zwierzętami chorującymi na różycę.
Zapobieganie zoonozom wymaga przestrzegania odpowiednich środków higieny, unikania bezpośredniego kontaktu z zakażonymi zwierzętami oraz stosowania się do zaleceń weterynarza w przypadku podejrzenia zarażenia. W przypadku występowania róży wśród zwierząt, istotne jest monitorowanie sytuacji oraz prowadzenie działań prewencyjnych, aby ograniczyć ryzyko przeniesienia zarażenia na ludzi.
XI. Nowe kierunki badań i innowacje
A. Nowe terapie i antybiotyki
W dziedzinie leczenia różycy prowadzone są badania nad nowymi terapiami i antybiotykami, które mogą być skuteczniejsze w zwalczaniu tej choroby. Przykładowo, badacze poszukują nowych leków przeciwbakteryjnych, które mogą być skuteczniejsze w zwalczaniu szczepów bakterii odpornych na obecne antybiotyki. Inne kierunki badań obejmują terapie wspomagające, które mogą poprawić skuteczność leczenia oraz skrócić czas rekonwalescencji pacjentów.
B. Rola szczepionek – czy są możliwe?
Pomimo braku komercyjnie dostępnej szczepionki przeciwko różycy, badania nad stworzeniem skutecznej ochrony szczepionkowej trwają. W przyszłości istnieje potencjał dla opracowania szczepionek zapobiegających zakażeniom różycą, co byłoby kluczowym krokiem w kontroli tej choroby, szczególnie w regionach o wysokim ryzyku występowania przypadków.
C. Diagnostyka molekularna i szybkie testy
Rozwój diagnostyki molekularnej i szybkich testów pozwala na szybsze i bardziej precyzyjne rozpoznanie różycy. Badania molekularne mogą pomóc w identyfikacji konkretnych szczepów bakterii oraz ich cech, co może być istotne przy wyborze odpowiedniej terapii. Szybkie testy diagnostyczne mogą również zwiększyć skuteczność i szybkość decyzji terapeutycznych, co ma kluczowe znaczenie w leczeniu chorych na różycę. Wprowadzenie nowoczesnych narzędzi diagnostycznych może przyspieszyć proces leczenia i ograniczyć ryzyko powikłań.
XII. Edukacja i profilaktyka w praktyce
A. Rola personelu medycznego

- Personel medyczny odgrywa kluczową rolę w edukacji pacjentów na temat różycy, zarówno podczas diagnozy, jak i w trakcie leczenia.
- Pracownicy służby zdrowia powinni dostarczać pacjentom dokładne informacje na temat objawów różycy, sposobów transmisji, konieczności leczenia oraz prewencji nawrotów.
- Ponadto, personel medyczny powinien być świadomy ryzyka zakażenia w swoim otoczeniu zawodowym i zastosować odpowiednie środki ostrożności, aby uniknąć zakażenia się oraz nieumyślnego przeniesienia choroby na innych.
B. Programy profilaktyczne
W ramach programów zdrowotnych i profilaktycznych konieczne jest promowanie odpowiednich zachowań, które zmniejszają ryzyko zakażenia różycą. Programy profilaktyczne mogą obejmować edukację dotyczącą higieny osobistej, zwłaszcza wśród dzieci i młodzieży, aby zminimalizować ryzyko zarażenia się bakterią powodującą różycę.
Istotne jest także zachęcanie do stosowania środków ochrony osobistej, zwłaszcza wśród osób pracujących w obszarach o zwiększonym ryzyku zakażenia, takich jak rolnicy, ogrodnicy czy weterynarze.
C. Edukacja zdrowotna społeczeństwa
Ważnym elementem walki z różycą jest szerzenie wiedzy na temat tej choroby wśród społeczeństwa. Edukacja zdrowotna powinna obejmować informowanie o objawach, ryzyku zakażenia, metodach ochrony oraz dostępnych metodach leczenia. Warto też edukować społeczeństwo na temat znaczenia regularnych badań profilaktycznych oraz wczesnego wykrywania choroby. Popularyzacja wiedzy na temat różycy może przyczynić się do zmniejszenia ryzyka zakażenia oraz poprawić wyniki leczenia poprzez szybsze reagowanie na pierwsze objawy choroby.
XIII. Studium przypadku
A. Przykład pacjenta z ostrą różycą kończyny dolnej
Pacjentem jest osoba, która rozwinęła ostrą postać różycy na kończynie dolnej. Objawy mogą obejmować czerwone, bolesne guzy, owrzodzenia, pęcherze oraz obrzęk. Może wystąpić gorączka, ból stawów i ogólne osłabienie. Pacjent może odczuwać intensywne dyskomfort i zmniejszenie sprawności ruchowej zakażonej kończyny.
B. Przebieg leczenia i rekonwalescencja
Leczenie ostrą różycy kończyny dolnej zazwyczaj obejmuje antybiotykoterapię pod nadzorem lekarza. Po zdiagnozowaniu choroby i zastosowaniu odpowiedniego leczenia, pacjent powinien poddać się regularnym badaniom kontrolnym, aby monitorować postęp w leczeniu i ewentualnie dostosować terapię w razie potrzeby. Rekonwalescencja może być czasochłonna i wymagać cierpliwości, a także przestrzegania zaleceń medycznych, takich jak dbanie o higienę oraz unikanie czynników predysponujących do nawrotów różycy.
C. Wnioski i nauka dla innych
W oparciu o ten przypadek pacjenta z ostrą różycą kończyny dolnej należy zwrócić uwagę na konieczność szybkiej reakcji w przypadku podejrzenia infekcji. Wczesna diagnoza i właściwe leczenie mogą znacząco wpłynąć na przebieg choroby i zapobiec powikłaniom.
Dla innych pacjentów jest to przypomnienie o konieczności regularnych kontroli stanu zdrowia oraz skutecznego postępowania w przypadku wystąpienia objawów infekcji, zwłaszcza na skórze. Warto także pamiętać o edukacji dotyczącej higieny osobistej i profilaktyki zakażeń, aby minimalizować ryzyko rozwinięcia różycy lub innych infekcji skórnych.
XIV. Podsumowanie
A. Najważniejsze informacje w skrócie
- Różycą jest bakteryjna infekcja skóry, której typowym objawem są czerwone, bolesne guzy lub pęcherze, najczęściej na nogach.
- Choroba może prowadzić do powikłań, dlatego ważne jest szybkie zdiagnozowanie i odpowiednie leczenie.
B. Dlaczego szybka reakcja ma znaczenie?
- Szybka reakcja jest kluczowa w przypadku różycy, ponieważ umożliwia wczesne zastosowanie skutecznej terapii.
- Opóźnienie w leczeniu może prowadzić do nasilenia objawów, powikłań, a nawet rozprzestrzenienia się infekcji na inne obszary ciała.
C. Zachowanie czujności i profilaktyki
- Ważne jest zachowanie czujności i regularne monitorowanie swojego stanu zdrowia skóry, zwłaszcza jeśli ma się skłonność do infekcji skórnych.
- Profilaktyka obejmuje dbanie o higienę, unikanie ran i skaleczeń, noszenie odpowiedniego obuwia oraz reagowanie natychmiast na pojawiające się objawy infekcji skórnej.
- Regularne wizyty u dermatologa mogą pomóc w wczesnym wykryciu potencjalnych problemów skórnych i podjęciu odpowiednich działań profilaktycznych.
XV. Najczęstsze pytania i odpowiedzi (FAQ)
A. Czy różyca to choroba zakaźna?
Tak, różycę wywołują bakterie z rodzaju Streptococcus, które mogą być przenoszone poprzez kontakt z zakażonymi osobami lub przedmiotami. Choroba jest zakaźna i mogą ją łatwo przenieść osoby mające kontakt z zakażonymi obszarami skóry.
B. Jak rozpoznać różycę we wczesnym stadium?
Różycę można rozpoznać we wczesnym stadium poprzez charakterystyczne objawy takie jak czerwone, bolesne guzy lub pęcherze na skórze, często występujące na nogach. Jeśli pojawią się podejrzenia infekcji skórnej, należy jak najszybciej skonsultować się z lekarzem.
C. Czy można zachorować ponownie?
Tak, możliwe jest zachorowanie na różycę ponownie, zwłaszcza jeśli organizm ponownie zostanie wystawiony na zakażenie tą bakteryjną infekcją. Ważne jest skuteczne leczenie infekcji oraz podejmowanie działań profilaktycznych w celu zapobiegania powtórnemu zachorowaniu.
D. Jakie są skutki nieleczonej różycy?
Nieleczone różycy może prowadzić do powikłań, takich jak rozprzestrzenienie się infekcji na inne obszary ciała, zapalenie naczyń limfatycznych, infekcje stawów czy nawet sepsa. Dlatego ważne jest jak najszybsze podjęcie leczenia po rozpoznaniu choroby.
E. Czy różycę można wyleczyć domowymi sposobami?
Leczenie różycy powinno odbywać się pod kontrolą lekarza, który zazwyczaj zaleca antybiotyki i inne specjalistyczne środki lecznicze. Nie zaleca się prób leczenia różnicy domowymi sposobami, ponieważ może to prowadzić do powikłań i opóźnienia w skutecznym leczeniu.
F. Czy różyca pozostawia blizny?
W większości przypadków, o ile infekcja zostanie skutecznie leczona, różyca nie pozostawia trwałych blizn. Jednak w przypadkach powikłań, szczególnie gdy dochodzi do głębokich zmian skórnych, mogą wystąpić blizny. Dlatego ważne jest szybkie leczenie oraz odpowiednia opieka nad skórą po zagojeniu się zmian.
Zioła w leczeniu chorób: Różyca (choroba)
Oto kilka ziół, które mogą być pomocne w leczeniu różnicy:
- Lawenda: posiada właściwości przeciwzapalne i łagodzące objawy skórne.
- Nagietek: działa przeciwzapalnie i przeciwbakteryjnie, pomagając w zwalczaniu infekcji skórnych.
- Rumianek: łagodzi podrażnienia skóry, działa kojąco i przeciwzapalnie.
- Mniszek lekarski: wspomaga gojenie ran i łagodzi opuchliznę skórną.
- Bazylia: działa antybakteryjnie i przeciwwirusowo, wspomaga proces gojenia się skóry.
- Pokrzywa: pomaga w oczyszczaniu organizmu z toksyn i wspomaga proces zdrowienia skóry.
- Rokitnik: bogaty w witaminę C, wspomaga układ odpornościowy i procesy regeneracji skóry.
- Szałwia: działa przeciwbakteryjnie i przeciwzapalnie, pomaga w zwalczaniu infekcji skórnych.
- Różeniec górski: wspomaga proces gojenia się ran i działa przeciwzapalnie.
- Kurkuma: posiada właściwości przeciwzapalne i antybakteryjne, korzystnie wpływa na zdrowie skóry.

Przed zastosowaniem jakichkolwiek ziół w leczeniu różnicy ważne jest skonsultowanie się z lekarzem lub zielarzem, aby uniknąć ewentualnych interakcji z lekami i dobrać odpowiednie metody leczenia.

